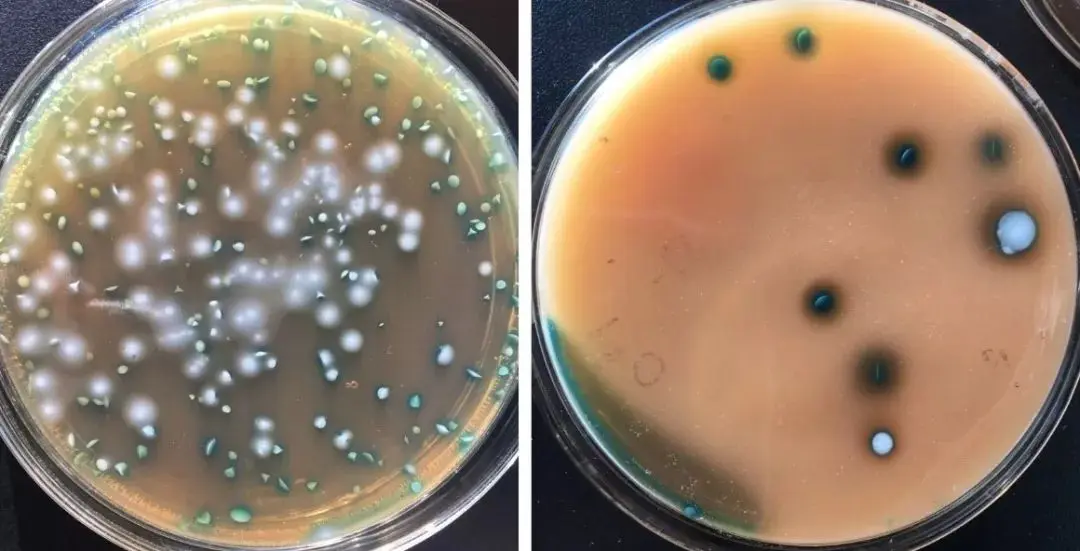
双歧杆菌在MRS筛选平板上的菌落形态

筛选与鉴定双歧杆菌方法及实验步骤!
发布时间:2023-06-06 浏览次数:4522
在人类的历史进程中,有这样的一类微生物,你肉眼看不到它,但它却默默地存在着。它们不仅存在,而且还发挥着极大的作用。今天我们就来简单说一下其中的某种肠道益生菌 — 双歧杆菌!
● 一、双歧杆菌到底长什么样
双歧杆菌,顾名思义,首先它是杆菌(杆菌?自己先脑补一下棍子的样子),而且是革兰氏阳性杆菌(革兰氏阳性菌最显著的特点是细菌被革兰染色后在显微镜下呈紫色)。而由于其末端常常分叉,故名为双歧杆菌。双歧杆菌肉眼是无法看到的,所以我们只能借助显微镜来看清它真实的面目。
双歧杆菌是1899年由法国Tissier博士从母乳营养儿的粪便中分离出的,不运动、无芽孢、形态多变的杆菌。最适生存温度为(37~42)℃,最适pH值6.5~7.0,广泛存在于人和动物的消化道、口腔等环境中。
● 二、双歧杆菌对人类的作用
这么微小的,需要借助显微镜才能看到的双歧杆菌到底对人类有什么用?
双歧杆菌是一种重要的肠道有益微生物。其作为一种生理性有益菌,对人体健康具有生物屏障作用、营养作用、免疫增强作用、改善胃肠道功能等多种重要的生理功能。双歧杆菌数量的多少,是判断人体健康的晴雨表。
不仅仅如此,双歧杆菌还能抑制人体有害细菌的生长,抵抗病原菌的感染,合成人体需要的维生素,促进人体对矿物质的吸收,促进排便、净化肠道环境、刺激人体免疫系统等,对促进人体健康发挥重要作用。
● 三、双歧杆菌的检测方法
既然它这么重要(so important),又这么微小(so small),那我们如何在平时食用的食品中检测它的存在?
下面简述双歧杆菌的选择性筛选和鉴定方法:

1、样品制备
1.1 样品的全部制备过程均应遵循无菌操作程序。
1.2 以无菌操作称取25g(mL)样品,置于装有225mL生理盐水的灭菌锥形瓶内,制成1:10 的样品匀液。
2、稀释及涂布培养步骤
2.1 用1mL 无菌吸管或微量移液器吸取1:10 样品匀液1.0mL,沿管壁缓慢注于装有 9mL生理盐水的无菌试管中(注意吸管尖端不要触及稀释液),振摇试管或换用1支无菌吸管反复吹打使其混合均匀,制成1:100的样品匀液。
2.2 另取1mL无菌吸管或微量移液器吸头,按2.1操作顺序,做10 倍递增样品匀液,每递增稀释一次,即换用1 次1mL灭菌吸管或吸头。
2.3 根据待鉴定菌种的活菌数,选择三个连续的适宜稀释度,每个稀释度吸取0.1mL 稀释液,接种在双歧杆菌琼脂平板或MRS琼脂平板,或取0.1mL适当稀释度的样品匀液均匀涂布在双歧杆菌琼脂平板或MRS琼脂平板。36℃±1℃厌氧培养48h±2h,可延长至72h±2h。
图1 双歧杆菌在MRS筛选平板上的菌落形态
3、纯培养:挑取3个或以上的单个菌落接种于双歧杆菌琼脂平板或MRS琼脂平板。36 ℃±1℃厌氧培养48h±2h,可延长至72h±2h。
4、菌种鉴定
4.1 涂片镜检:挑取双歧杆菌平板或MRS平板上生长的双歧杆菌单个菌落进行染色。双歧杆菌为革兰氏染色阳性,呈短杆状、纤细杆状或球形,可形成各种分支或分叉等多形态,不抗酸,无芽孢,无动力。
图2 双歧杆菌在显微镜下的形态观察

4.2 生化鉴定:过氧化氢酶试验为阴性。选取纯培养平板上的三个单个菌落,分别进行生化反应检测,不同双歧杆菌菌种主要生化反应见表1:


● 四、应用讨论
双歧杆菌在人类食品、医药和保健等领域已经得到较广泛的应用,而在动物或畜禽等应用相对有限。限制其应用的主要因素包括:菌株来源不明确,黏附特异性和定植效率低;对氧气和温度环境敏感,耐氧性及稳定性低,不利于生产和实际应用;发酵条件要求高,发酵水平低,工业生产成本压力大等。因此,筛选具有良好技术性能,包括耐氧、耐热、耐酸耐胆盐及良好发酵性能菌株对后期生产和应用具有重要意义。
说明:转载只为分享目的,如有侵权或不愿小编转载发布请联系删除,谢谢!











